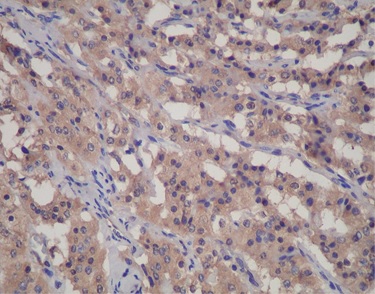
よくある質問

フォン ヒッペル リンダウ症候群は、体のさまざまな部分で嚢胞や腫瘍の増殖を引き起こす、まれな遺伝性疾患です。
フォン ヒッペル リンダウ症候群の人に発生する腫瘍は通常は良性ですが、癌性の場合もあります。治療法は腫瘍の大きさと位置によって異なります。
人は生まれつきそれを持っていますが、症状は若い成人期に現れる傾向があります。
この記事では、フォン ヒッペル リンダウ症候群、その症状、原因、医師によるこの状態の診断方法、および治療の選択肢について概説します。
フォン ヒッペル リンダウ症候群、または VHL 症候群は遺伝性の疾患です。これはまれであり、米国で罹患している人は 50,000 人未満です。 VHL 遺伝子の変異がその原因です。
VHL 症候群は、次のような体のさまざまな領域に嚢胞や腫瘍を引き起こします。
- 脳
- 目
- 脊髄
- 副腎
- 膵臓
- 腎臓
- 内耳
- 生殖器官
VHL 症候群は通常、良性の嚢胞を引き起こしますが、腫瘍は癌性である場合もあります。
実際、VHL 症候群のある人は、そうでない人に比べて、腎臓がんなどの特定の種類のがんを発症するリスクが高くなります。
フォン ヒッペル リンダウ症候群の人が経験する症状は、腫瘍の位置と大きさによって異なります。
それらには次のものが含まれる場合があります。
- めまい
- 頭痛
- 視力の問題
- 高血圧
- 歩行困難またはバランスの問題
- 片耳の難聴
- 手足の衰弱
フォン ヒッペル リンダウ症候群は常染色体優性遺伝病です。これは、人が VHL 症候群を継承するには、どちらかの生みの親から、変異した VHL 遺伝子のコピーを 1 つだけ受け取ればよいことを意味します。
場合によっては、VHL 遺伝子に自然発生的に突然変異が発生し、これが病気を引き起こす可能性もあります。
VHL 遺伝子は腫瘍抑制遺伝子であり、細胞の急速な増殖や制御不能な増殖を阻止します。遺伝子の変異により、異型の VHL タンパク質が生成され、細胞の分裂と成長に影響を与えます。その結果、細胞の増殖が速すぎたり、制御不能になったりして、嚢胞や腫瘍が形成されることがあります。
VHL 症例の約 20% は初家族症例です。
一般に、フォン・ヒッペル・リンダウ症候群の診断には分子遺伝学的検査が必要です。この検査では、病気の原因となる可能性のある VHL 遺伝子の変異体や変異がないかどうかを調べます。
医師は画像検査を使用して、体のどこかに腫瘍が発生していないかどうかを確認することもあります。腫瘍が VHL 症候群に特徴的な腫瘍を示している場合に診断が行われます。
VHL 症候群の診断を受けると、モニタリングが必要になります。
フォン ヒッペル リンダウ症候群の治療法は、その人が経験する症状、一般的な健康状態、腫瘍の位置によって異なります。
脳と脊髄
脊髄または脳に腫瘍が発生した場合、医師はそれらを除去する手術を勧める場合があります。これにより、嚢胞や腫瘍が収縮し、脳、脊髄、またはその近くの領域に圧力がかかるのを防ぎます。
場合によっては、専門家が放射線手術を受けることを勧めることもありますが、この処置は通常、時間の経過とともにあまり良い効果をもたらしません。
目
目に腫瘍が発生した場合は、レーザー手術または凍結療法を使用して視力喪失を防ぐことができます。
副腎
副腎に嚢胞が形成された場合、医師は腹腔鏡下副腎部分切除術による副腎の部分切除を推奨する場合があります。
腎臓と膵臓
腎臓の VHL 腫瘍は、そのサイズと成長の速さに応じて、放射線療法または凍結療法が必要な場合があります。これらの両方の要因は、腫瘍が体中に広がり始めているかどうかを示唆している可能性があります。
膵臓に腫瘍が発生した場合、その種類によっては治療が必要ない場合があります。ただし、膵臓神経内分泌腫瘍を発症した場合は、治療が必要になります。医師は腫瘍の大きさ、成長速度、患者が持つ VHL 遺伝子変異を事前に考慮します。
薬
食品医薬品局(FDA)も最近、ベルズティファン(ウェリレグ)と呼ばれるフォン・ヒッペル・リンダウ症候群の初の全身治療法を承認した。膵臓、腎臓、中枢神経系の腫瘍の治療に役立ち、緊急の手術が必要になるのを防ぎます。
それでも、腫瘍の外科的除去は依然として VHL 患者にとっての主要な治療法です。
VHL の診断を受けた人は、定期的な健康診断に出席し、新たな腫瘍や嚢胞の形成を調べる監視検査を受ける必要があります。ほとんどの病変は小さく、治療が簡単ですが、一部の病変は重篤な健康上の問題を引き起こす可能性があります。
一般に、フォン ヒッペル リンダウ症候群の人は、長く充実した人生を送ることができます。ただし、病気の重症度や腫瘍の発生場所によっては、重大な病気を引き起こす場合があります。
フォン ヒッペル リンダウ症候群に関してよくある質問は次のとおりです。
フォン ヒッペル リンダウ症候群の症状は何ですか?
フォン ヒッペル リンダウ症候群の症状はさまざまですが、次のようなものがあります。
- めまい
- バランスや歩行の困難
- 手足の衰弱
- 高血圧
- 片耳の難聴
- 視力の問題
- 頭痛
フォン・ヒッペル・リンダウ病の人の平均余命はどれくらいですか?
平均余命は生物学的男性で67歳、生物学的女性で60歳です。
しかし、新しい薬や治療技術は進歩しており、VHL 症候群の人々により良いサポートを提供できるようになりました。これは寿命にも影響を与える可能性があります。
フォン・ヒッペル・リンダウは治療可能ですか?
現在、フォン・ヒッペル・リンダウ症候群の治療法はありません。ただし、症状を管理し、合併症のリスクを軽減するのに役立つ治療法がいくつかあります。
フォン ヒッペル リンダウ (VHL) 症候群は、体のいくつかの領域に嚢胞や腫瘍の形成を引き起こす、まれな遺伝性の病気です。これらの腫瘍は多くの場合良性ですが、場合によっては癌性である可能性があります。このため、VHL の診断を受けた後は、新たな成長を見つけるために定期検査を受ける必要があります。
VHL 患者は、腫瘍が発生する場所に応じてさまざまな症状を経験することがあります。これには、めまい、視力の問題、平衡感覚の問題、難聴などが含まれる場合があります。 VHL には治療法はありませんが、手術と新しい全身薬は病気の症状を管理し、合併症を防ぐのに役立ちます。
フォン・ヒッペル・リンダウ症候群について知っておくべきこと・関連動画
参考文献一覧
- https://rarediseases.org/rare-diseases/von-hippel-lindau-disease/#causes
- https://www.ncbi.nlm.nih.gov/books/NBK599772/
- https://www.ninds.nih.gov/health-information/disorders/von-hippel-lindau-disease-vhl
- https://www.cancer.gov/publications/dictionaries/cancer-terms/def/von-hippel-lindau-syndrome
- https://rarediseases.info.nih.gov/diseases/7855/von-hippel-lindau-disease
- https://pubmed.ncbi.nlm.nih.gov/27539272/
- https://rarediseases.org/rare-diseases/von-hippel-lindau-disease/